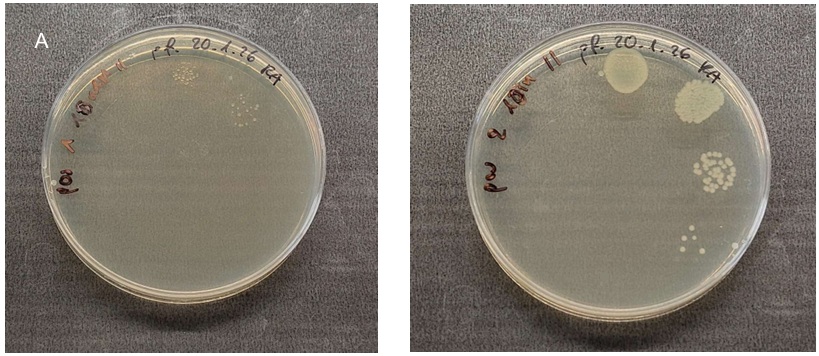

Hinter den Kulissen - Einblick ins Blaulicht-Labor
Im Laser Zentrum Hannover e. V. wurden bisher Laborversuche mit Blaulichtbestrahlung von Salaten und Blaubeeren durchgeführt. Diese fanden zunächst in einer kleinen „Blaulichtkammer“ statt und werden aktuell mit dem Blaulichtmodul fortgeführt, dass später auch in den Betrieben zum Einsatz kommen wird. Ziel ist die Reduktion von Verderb verursachenden Bakterien auf der Lebensmitteloberfläche, um deren Haltbarkeit zu erhöhen. Davon profitiert nicht nur der produzierende Betrieb, es fallen auch weniger Lebensmittelabfälle an.
Versuche im Labor - Feststellung der Bakterien und erste Bestrahlung
Für die Versuche im Winter wurde zunächst mit Blaubeeren und aus dem Supermarkt gearbeitet. Ab der Blaubeersaison im kommenden Sommer werden die Beeren des Projektpartners „Obsthof Rieke“ für die Versuche genutzt.
Der Projektpartner „Permakultur Kirchhorst“ konnte ihre Wintersalatmischung „Rocket“ für das Labor zur Verfügung stellen.
Die Oberfläche von Salat und Blaubeeren wird mit einem Tupfer abgerieben. Die darauf haftenden Keime werden auf das Nährmedium „Agrar-Agar“ in einer Petrischale aufgebracht, um eine Bakterienkultur anzulegen.
Parallel dazu werden die Salat- und Blaubeerproben in ein Reagenzglas mit Kochsalzlösung gegeben. Die anhaftenden Bakterien lösen sich so von der Oberfläche der Proben. Mit einem speziellen Gerät wird eine PCR-Analyse durchgeführt. Diese bestimmt die genauen Bakterienarten, die sich auf der Oberfläche der Proben befunden haben.

Von den auf Salat und Blaubeeren festgestellten Bakterien wurden insgesamt sechs für die Behandlung mit Blaulicht ausgewählt. Diese sind relevant für die jeweiligen Kulturen, kommen allerdings auch auf sehr vielen anderen Obst- und Gemüsearten vor.
Es handelt sich um jeweils drei grampositve und drei gramnegative Bakterien, die Verderb auslösen und/oder sich bei übermäßigem Vorhandensein negativ auf die menschliche Gesundheit auswirken können (z. B. E. coli). Grampositive und -negative Bakterien unterscheiden sich u. A. in der Dicke ihrer Zellwand und damit der Empfindlichkeit gegenüber für sie schadhaften Einflüssen, wie z. B. Antibiotika. Im Labor wird dieser Unterschied durch eine so genannte Gram-Färbung festgestellt. Grampositive Bakterien haben am Ende der Analyse eine blau-violette Farbe, gramnegative werden rosa bis rot.
Es wurden behandelt:
gramnegativ
– Pseudomonas fluorescens (empfindlich ggü. Blaulicht, zum Vergleich)
– Pseudomonas sp. (auf Salat gefunden)
– Escherichia coli K12 (Kontamination durch Düngen)
grampositiv
– Staphylococcus aureus (auf Obst/ Gemüse nach Kontakt mit Händen )
– Bacillus subtillis (Verderbniskeim, auf Beeren und Salaten)
– Listeria monocytogenes (Verderbniskeim, auf Blattgemüse und Beeren)
Vorstellung Pseudomonas fluorescens
Es handelt sich hierbei um ein gramnegatives, stäbchenförmiges Bakterium und einen typischen Verderbniserreger frischer
Lebensmittel. Weiter reagiert es empfindlich auf Blaulicht und wurde daher als „Standard“ für die Versuche ausgewählt. Es gehört zur Gruppe der „psychotropen“ Mikroorganismen. Das bedeutet, dass es zwar moderate Temperaturen und Feuchtigkeit bevorzugt, sich aber auch bei Kühlschranktemperaturen von 0– 7 °C effizient vermehren kann. Durch seine Kältetoleranz wird es auch in der Kühlkette zu einem dominanten Verderbniserreger. Es ist in der Lage, einen Biofilm zu bilden, der teilweise vor Desinfektionsmitteln mechanisch und chemisch geschützt ist. Dies stellt in der Lebensmittelverarbeitung ein erhebliches Risiko dar.
Durch die hohe Wachstumsrate kann es in frisch verpackten Lebensmitteln die natürliche
Begleitflora verdrängen, sofern keine Atmosphären mit hohem CO2-Gehalt eingesetzt werden (können).
Vorgehen bei der Bestrahlung mit Blaulicht
Bei den Laborversuchen wurden sowohl die Bakterien in einer Petrischale, als auch die Bakterien auf der Oberfläche von Blaubeeren und Salat bestrahlt. In der Petrischale können die Bakterien vor und nach der Behandlung mit Blaulicht ausgezählt werden. Damit lässt sich die Wirkung sehr genau feststellen. Die direkte Behandlung mit Blaulicht wurde zunächst mit einer Wellenlänge von 405 nm eine Stunde lang durchgeführt. Die genutzte Lampe hatte 195 mW (0,195 Watt) Leistung, so dass insgesamt eine Energiemenge von 702 J/cm² aufgewendet wurde.
Die Wellenlänge von 405 nm liegt im sichtbaren violett-blauen Bereich des Lichts.



Dieses Licht hat genug Energie, um bestimmte lichtempfindliche Moleküle in Bakterien zu aktivieren – sogenannte endogene Photosensibilisatoren. Diese Moleküle kommen natürlicherweise in vielen Bakterien vor (besonders gram-positive Bakterien). Die Aktivierung durch das Blaulicht führt über die Bildung von einer reaktiven Sauerstoffspezies (ROS) zur Schädigung der DNA, Zellmembran und Proteinstrukturen der Zelle und führt zu einer starken Schädigung bzw. dem Absterben des Bakteriums.

Wie in der nebenstehenden Tabelle zu sehen, konnten unter den Laborbedingungen bis zu 99 % der Keime in der Petrischale mit Blaulichtbestrahlung abgetötet werden.
Nach der Dauerbestrahlung wurden auch verschiedene „Lichtintervalle“ getestet, angepasst an den Reproduktionszyklus der Bakterien (z. B. 10 min an, 30 min aus in „Dauerschleife“). Die frischen Ernteprodukte der Praxisbetriebe wurden desinfiziert und gezielt mit den einzelnen Keimen inokuliert, um diese direkt am Produkt behandeln zu können.
Die intermittierende Bestrahlung (Das „Lichtintervall) hat bei diesen Versuchen in mehreren Fällen besser abgeschnitten als die Dauerbestrahlung.
Es wurden hierbei 40 Minuten Blaulichtbestrahlung mit einem Intervall von 10 Minuten Blaulicht und 30 Minuten mit ausgestellter Beleuchtung verglichen. Das letzte Muster wurde vier Mal wiederholt, sodass in beiden Fällen die Blaubeeren 40 Minuten lang dem Blaulicht ausgesetzt waren. Dieser Zyklus wurde gezielt an die Vermehrung der Bakterien angepasst und zeigt einen deutlich höheren Erfolg bei Pseudomonas
flourescens und Bacillus subtillis. Bei Listeria monocytogenes wurde dieser Effekt nicht sichtbar, was mit dem längeren Reproduktionszyklus des Bakteriums zusammenhängen könnte. Hierzu finden derzeit gesonderte Versuche mit einer angepassten Belichtungsdauer statt.
Neben der höheren Wirksamkeit hat die Verwendung eines Belichtungsintervalls den Vorteil, dass diese Variante weniger Energiekosten benötigt und eine geringere Wärmeentwicklung stattfindet. Je länger die Lagerung dauert, desto höher wirken sich diese Vorteile aus.
Einsatz des Blaulicht-Moduls im Labor
In den letzten Monaten hat Laser Zentrum Hannover e. V. das Belichtungsmodul für die Blaubeeren vom Obsthof Rieke entwickelt, welches abgewandelt auch in den Verkaufskühlschränken der Permakultur Kirchhorst verwendet werden kann.
Das entwickelte Blaulichtmodul deckt zwei Obstkisten mit den Maßen
300 x 400 mm (DIN EN 13117) ab. Es wurden 32 dimmbare LED´s pro Kiste mit einer Wellenlänge von 405 nm verbaut. Die LED´s haben 4 cm untereinander, so dass eine gleichmäßige Verteilung über die Fläche besteht. Die optische Leistung aller LED´s beträgt 4,9 Watt.
Die Leistung ist stufenweise dimmbar und es können Programme für intermittierendes Licht eingestellt werden. Gekühlt wird der Demonstrator mit 16 VDC-Lüftern, je acht ein- und ausströmend.

Mit dem Demonstrator wurden mit dem zuvor vorgestellten Bakterium Pseudomonas fluorescens sowohl Bakterienkolonien in Petrischalen, als auch inokulierte Blaubeeren bestrahlt.
Unter dem Demonstrator gibt es zwei „Ausleuchtungszonen“: Position 1, mittig mit einer Leistung von 96,5 mW/cm2 sowie Postion 2, die am Rand zu finden ist. Hier beträgt die Leistung durch die fehlenden LED´s „rundherum“ dagegen 39,8 mW/cm2.
Bei einer Belichtungsstärke von 80 % konnte in der Petrischale nach 15 min Dauer eine Reduktion von 100 % der Bakterien auf Position 1 festgestellt werden. Nach 30 min sind auf Position 2 etwa die Hälfte der Bakterien nicht mehr vorhanden.
Das Beispiel auf der linken Seite zeigt je eine Kultur auf Position 1 und 2 nach zehnminütiger Bestrahlung – links die Position 1, auf dem rechten Bild Position 2. Es ist ersichtlich, dass mit höherer Belichtungsstärke mehr Bakterien reduziert werden können.
Bei der intermittierenden Bestrahlung zeigte sich derselbe Erfolg wie zuvor ohne den Demonstrator: Bei gleicher „Nettodosis“ der Belichtung konnte die Anzahl der verbliebenen Bakterien deutlich reduziert werden. Bei den inokulierten Blaubeeren verringert sich der Bestrahlungserfolg durch Beschattungseffekte, Oberflächenstruktur und dadurch, dass nur die obere Schicht bestrahlt wird.
Weiteres Vorgehen
Der Demonstrator wird derzeit im Labor mit dem Bakterium Pseudomonas fluorescens mit verschiedenen Belichtungsstärken und – intervallen auf Blaubeeren getestet.
Auf der linken Seite ist die Belichtung bei 10 % zu sehen, auf der rechten Seite bei 100 % Leistung.
In der kommenden Zeit folgen weitere Keime und Schimmelpilze. Zur kommenden Saison wird das Blaulichtmodul auf die Betriebe verbracht, um vor Ort größere Mengen zu bestrahlen. Weiter soll festgestellt werden, ob das Verfahren auch bei mechanischer Bewegung der Früchte funktioniert und auf einem Förderband einsetzbar ist.
